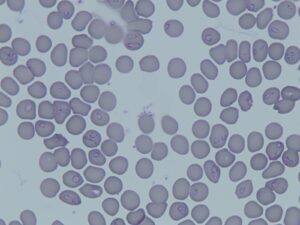

JOHNNY YUE
Yale School of Public Health partners with Cambodia to establish health economics training program
The MPH-HEF program will help students gain expertise on health economics and financing.
April 18, 2024